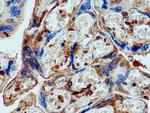
pregnancy zone protein Antibody in Immunohistochemistry (Paraffin) (IHC (P))

Search
Proteintech
pregnancy zone protein Polyclonal Antibody
{{$productOrderCtrl.translations['antibody.pdp.commerceCard.promotion.promotions']}}
{{$productOrderCtrl.translations['antibody.pdp.commerceCard.promotion.viewpromo']}}
{{$productOrderCtrl.translations['antibody.pdp.commerceCard.promotion.promocode']}}: {{promo.promoCode}} {{promo.promoTitle}} {{promo.promoDescription}}. {{$productOrderCtrl.translations['antibody.pdp.commerceCard.promotion.learnmore']}}
图: 1 / 9
pregnancy zone protein Antibody (21742-1-AP) in IHC (P)

产品信息
21742-1-AP
种属反应
宿主/亚型
分类
类型
抗原
偶联物
形式
浓度
纯化类型
保存液
内含物
保存条件
运输条件
产品详细信息
Immunogen sequence: ITAHYTLNR QAMGELSELS FHYLIMAKGV IVRSGTHTLP VESGDMKGSF ALSFPVESDV APIARMFIFA ILPDGEVVGD SEKFEIENCL ANKVDLSFSP AQSPPASHAH LQVAAAPQSL CALRAVDQSV LLMKPEAELS VSSVYNLLTV KDLTNFPDNV DQQEEEQGHC PRPFFIHNGA IYVPLSSNEA DIYSFLKGMG LKVFTNSKIR KPKSCSVIPS VSAGAVGQGY YGAGLGVVER PYVPQLGTYN VIPLNNEQSS GPVPETVRSY FPETWIWELV AVNSSGVAEV GVTVPDTITE WKAGAFCLSE DAGLGISSTA SLRAFQPFFV ELTMPYSVIR GEVFTLKATV L (341-690 aa encoded by BC111756)
靶标信息
The protein encoded by this gene is highly expressed in late-pregnancy serum and is similar in structure to alpha-2-macroglobulin. The encoded protein, which acts as a homotetramer, inhibits the activity of all four classes of proteinases. This protein contains cleavage sites for several proteinases. Upon binding of a proteinase, the conformation of this protein changes to trap the proteinase, limiting its activity. This protein appears to be elevated in the sera of presymptomatic Alzheimer's disease patients.
仅用于科研。不用于诊断过程。未经明确授权不得转售。
生物信息学
蛋白别名: C3 and PZP-like alpha-2-macroglobulin domain-containing protein 6; Pregnancy zone protein; pregnancy-zone protein
基因别名: CPAMD6
Entrez Gene ID: (Human) 5858




